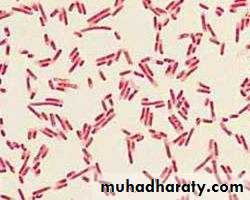
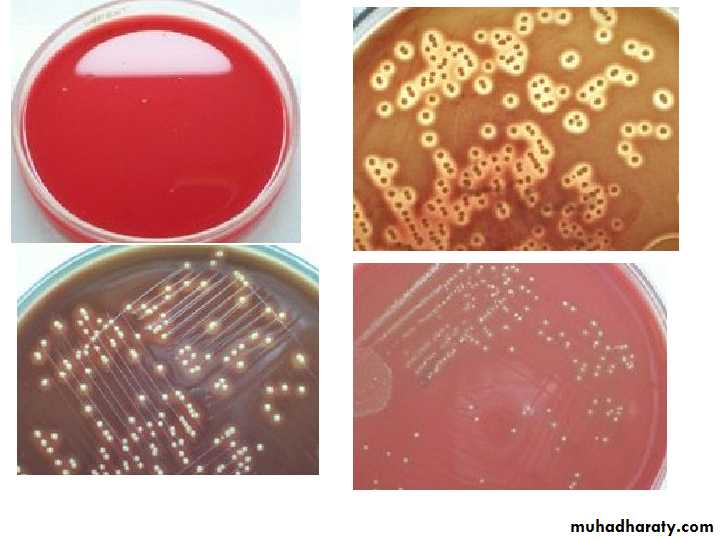

BACTERIAL PHYSIOLOGY Dr. Waleed Khalid Saadoon Lec. : 2
• Welcome To
• Meet the Microbes!
• Coccus
• Bacillus
• Vibrio
Spirillum Mycoplasma
It’s the growth, nutrition, Andmetabolism OF BACTERIAWhat does physiology means ?
1-BACTERIAL GROWTH
It is an increase in all the cellular components, which end in multiplication of the cell leading to an increase in population.It involves an increase in the number of individual cells.
Bacteria divide by binary fission.• Binary Fission
Generation time
Interval of time between two cell divisionsOR
The time required for a bacterium to give rise to 2 daughter cells under optimum conditions
Generation time of E.coli & other medically important bacteria is 20 mins
For tubercle bacilli is 20 hrsFor lepra bacilli is 20 days
Colony – formed by bacteria growing on solid media.Each bacterial colony represents a clone of cells derived from a single parent cell.
FACTORS AFFECTING BACTERIAL GROWTH INCLUDE:
• Temperature• Atmosphere – O2 & CO2
• H-ion concentration
• Moisture & drying
• Osmotic effects
• Radiation
• Mechanical & sonic stress
1-Temperature
Bacteria vary in their temperature requirements.Temperature range – growth does not occur above the maximum or below the minimum.
Optimum Temperature – It is the temperature at which growth occurs best, it is 37ºC for most pathogenic bacteria
CLASSIFICATION BASED ON TEMP.
Mesophilic – grows best between 25ºC and 40ºC.e.g. most pathogenic bacteria
Psychrophilic (cold loving) – grows best below 20ºC
e.g. Flavobacterium spps
Thermophilic – grows best at high temp, 55- 80ºC e.g. Bacillus sterothermophilus
2-OXYGEN
• Depending on the O2 requirement, bacteria are divided into :• Strict (Obligate) Aerobes – require O2 for growth e.g. Pseudomonas aeruginosa
• Strict (Obligate) Anaerobes – grow in the absence of O2 & may even die on exposure to O2 e.g. Bacteroides fragilis
• Microaerophilic – grow best in the presence of low oxygen levels
• e.g. Campylobacter spp, Helicobacter spp
7
• 4.Facultative anaerobe – aerobic but can also grow in the absence of O2
• e.g. Staphylococcus spps• 5.Aerotolerant anaerobe – anaerobic, but tolerates exposure to O2
• e.g. Clostridium perfringens
• 6.Capnophilic organism – requires high CO2 levels eg Neisseria spps
• The Effect of Oxygen (O2) on Growth
Needs oxygenGrows best in oxygen, but can grow without it
Only grows without oxygen
Grows in low concentrations of oxygen
Grows with or without oxygen
3- H-ion Concentration
pH range, optimum pH
Majority of pathogenic bacteria grow best at neutral or slightly alkaline pH (7.2 – 7.6) .
Lactobacilli require acidic pH
Vibrio cholerae require alkaline pH
4- Moisture and drying
Water is an essential ingredient of bacteria. Hence drying is lethal to cells.Effect of drying varies :
Trepanoma pallidum are highly sensitive to dryingStaphylococcus spp. withstand drying for months
Spores are resistant to drying and may survive for several decades
• 5- Osmotic effects
• More tolerant to osmotic variation due to mechanical strength of their cell walls.• 6- Radiation
• X rays & gamma rays exposure – lethal
• 7- Mechanical & Sonic Stress
• May be ruptured by mechanical stress.
BACTERIAL GROWTH CURVE
When a bacterium is added to a suitable medium & incubated, its growth follows a definite course.
If bacterial counts are made at intervals after inoculation & plotted in relation to time, a growth curve is obtained.
Growth curve shows 4 phases : Lag, Log or Exponential, Stationary & phase of Decline.
PHASES OF GROWTHLag phase – no increase in number but there may be an increase in the size of the cell.
Log or Exponential phase – cells start dividing and their number increases exponentially.
Stationary phase – cell division stops due to depletion of nutrients & accumulation of toxic products.
- Equilibrium exists between dying cells and the newly formed cells, so viable count remains stationary
Phase of decline – Population decreases due to the death of cells – autolytic enzymes.
BACTERIAL COUNTS
Growth in numbers can be studied by bacterial counts.
2 methods – Total cell count
- Viable cell countTOTAL COUNT
• Total number of cells in the sample – living + dead.• Can be obtained by :
• Direct counting under microscope using counting chambers.
• Counting in an electronic device – Coulter counter.
Viable Cell Count
• Measures the number of living cells.• Methods – Surface colony count
• Dilution method
• Plating method
• Number of colonies that develop after incubation gives an estimate of the viable count.
2-Bacterial Nutrition
Water constitutes 80% of the total weight of bacterial cells.Proteins, polysaccharides, lipids, nucleic acids & low molecular weight compounds make up the remaining 20%.
For growth & multiplication, the minimum nutritional requirements are water, a source of carbon, a source of nitrogen & some inorganic salts
Classification based on nutrition
• Based on nutrition , bacteria are classified as :• Autotrophs – can synthesize all their organic compounds by utilizing atmospheric CO2 & N2. They have no medical importance.
• Heterotrophs – unable to synthesize their own metabolites & depend on the organic compounds.
• All pathogenic bacteria are heterotrophs .
Nutritional Factors
• Some bacteria require certain organic compounds in minute quantities called as nutritional factors .• It can be :
• Essential – Compounds that bacterial growth does not occur in their absence.
• Accessory – Compounds that enhance growth but without being absolutely necessary for it
Based on Nutritional Requirement Bacteria Can Be Classified As:
• Phototrophs – Bacteria which derive their energy from sunlight.• Chemotrophs – Bacteria which derive energy from chemical reactions.
• Organotrophs : require organic sources of hydrogen
• Lithotrophs : require inorganic sources of hydrogen like NH3, H2S
OTHER GROWTH REQUIREMENTS
• Vitamin B complex –• Thiamine
• Riboflavine
• Nicotinic acid
• Pyridoxine
• Folic acid
• Vit.B 12
• 3-Bacterial Metabolism
• Types of Metabolism:• Metabolism is the totality of chemical reactions occurring in bacterial cells.
• They can be subdivided into :
• A- Catabolic reactions that supply energy.
• B- Anabolic (synthetic) reactions that consume energy
-Catabolic reactions supply both energy and the basic structural elements for the synthesis of specific bacterial molecules.
-In the anabolic reactions , the energy requirement is consumed in form of light or chemical energy—by photosynthetic or chemosynthetic bacteria, respectively.
A-Catabolic Reactions
-Organic nutrient substrates are catabolized in a wide variety of enzymatic processes that can be schematically divided into three phases:1-Digestion:
-Bacterial exoenzymes split up the nutrient substrates into smaller molecules outside the cell.
The exoenzymes represent important pathogenicity
factors in some cases.
2-Uptake:
-Nutrients can be taken up by means of passive diffusion or, more frequently, specifically by active transport through the membrane(s).3-Oxidation:
-This process is defined as the removal of electrons and H+ ions.-The substance to which the H2 atoms are transferred is called the hydrogen acceptor.
-The two basic forms of oxidation are defined by the final hydrogen acceptor:
A – Respiration:
-A series of reactions that convert glucose to CO2 and allow the cell to recover significant amounts of energy- Glucose + O2 Carbon dioxide + Water +Energy
- C6H12O6 + O2 6CO2 + 6H2O + 38 ATP
B-Fermentation:
-Here an organic compound serves as the hydrogen acceptor.-The main difference between fermentation and respiration is the energy yield, which can be greater from respiration than from fermentation for a
given nutrient substrate by as much as 10 times .